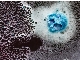
ضد کف و آنتی فوم آکریلیک(پایه آب و حلال) + نمونه رایگان

دیسپرسکننده نساجی | افزایش یکنواختی رنگ و پایداری پارچه
دیسپرسکننده نساجی، در دو نوع پودری و مایع (پایه آب) با فرمولاسیون پایه PNS عرضه میشود. این ماده با توزیع یکنواخت رنگ در الیاف، باعث افزایش کیفیت، ثبات رنگ پارچه و بهبود عملکرد فرایند رنگرزی میشود.
اطلاعات تامین کننده
کیمیا پتروشیمی دانشمند
کرجتولید کننده، عمده فروش، صادر کننده
مواد اولیه شیمیایی، شیمیایی، پتروشیمی، صادر کننده، تولید کننده، ضد کف، عمده، بایوساید ایزوتیازولین، پلی آلومینیوم کلراید (PAC)، پلی الکترولیت
مشاهده سایت فروشندهخرید از تامین کنندگان برتر پارس سنتر!

تامین کنندگان برتر پارس سنتر سرعت پاسخگویی بالاتر و محصولات بروز تری نسبت به سایر تامین کنندگان دارند.
مشخصات
- شرکت سازنده
- کیمیا پتروشیمی دانشمند
- کشور سازنده
- ایران
توضیحات محصول
دیسپرس کننده نساجی یکی از افزودنیهای کلیدی در صنعت رنگرزی است. این محصول که در شکلهای پودری یا مایع و با پایه آب یا پایه PNS عرضه میشود، با کاهش نیروهای کشش سطحی بین رنگ و الیاف، توزیع رنگ را یکنواخت میکند و بهعنوان مایع افزودنی رنگ باعث افزایش کیفیت، پایداری و ثبات رنگ در پارچه میشود.
ارسال سفارشها از کارخانه اشتهارد یا انبار شورآباد تهران انجام میشود.
تولید سفارشی مطابق فرمولاسیون مورد نیاز هر صنعت انجام میشود.
دارای گواهینامههای ISO 9001، ISO 10002 و ISO 10004 از SGS سوئیس.
عضو رسمی اتاق بازرگانی و اتحادیه مواد اولیه شیمیایی البرز.
برای دریافت MSDS، نمونه رایگان یا استعلام قیمت روز، به وبسایت ما مراجعه کنید.
🌐ورود به سایت
📞 0261817